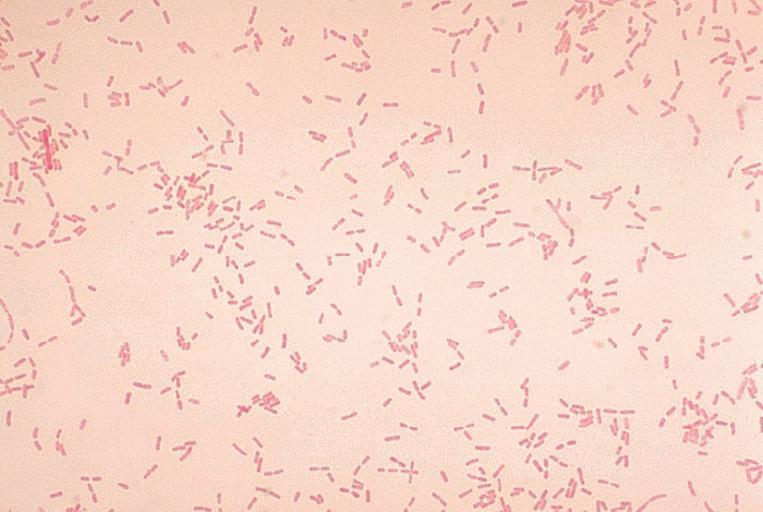

MAKE A MEME
View Large Image
| View Original: | 11G0002_lores.jpg (700x470) | |||
| Download: | Original | Medium | Small | Thumb |
| Courtesy of: | commons.wikimedia.org | More Like This | ||
| Keywords: 11G0002 lores.jpg Alcaligenes faecalis Gram stain Copyright Restrictions None - This image is in the public domain and thus free of any copyright restrictions As a matter of courtesy we request that the content provider be credited and notified in any public or private usage of this image http //phil cdc gov/Phil/details asp Public Health Image Library PHIL in Centers for Disease Control and Prevention image id 1250 Creation Date 1977 CDC/ Dr W A Clark PD-USGov Original upload log page ru wikipedia 11G0002_lores jpg 2009-03-22 08 18 VSGI 700×470× 79998 bytes <nowiki>Alcaligenes faecalis Gram stain </nowiki> Alcaligenes faecalis | ||||